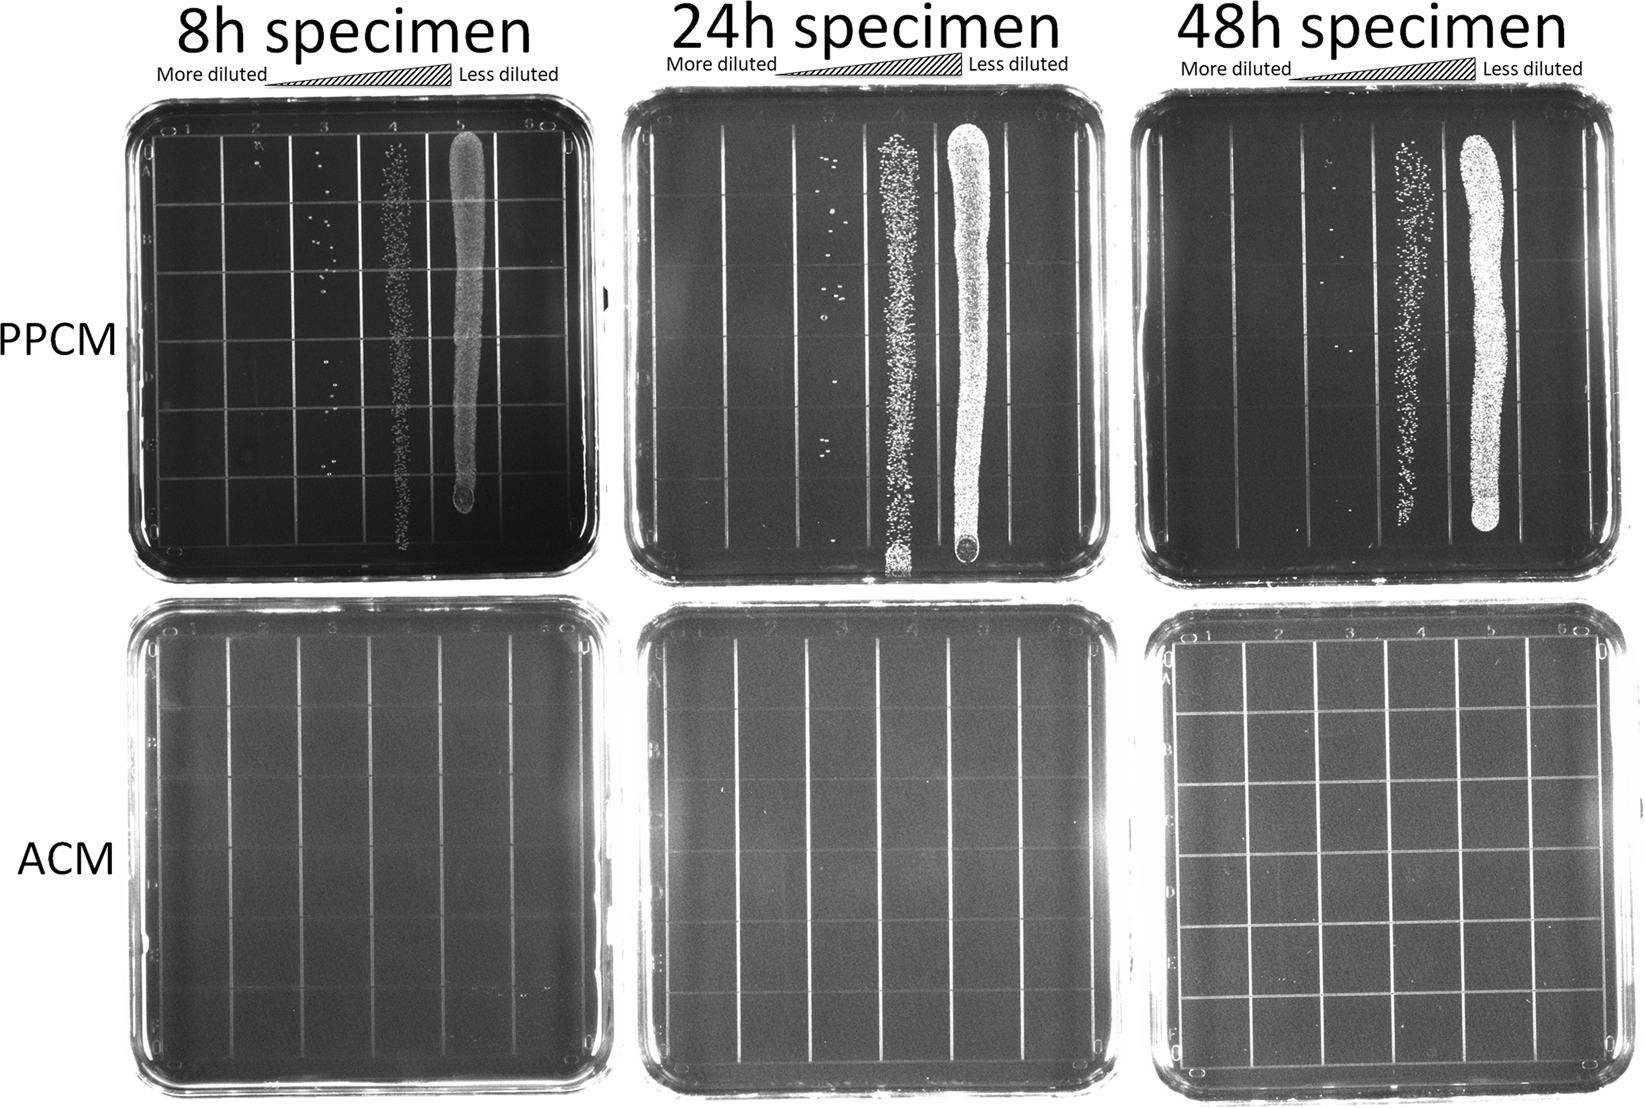
Figure 5

Figure 5
From: Antimicrobial Efficacy Assessment of Human Derived Composite Amnion-Chorion Membrane
Viable count recovery assays. The upper panel: live S. gordonii on PPCM at various dilutions; the lower panel: no live S. gordonii cells on ACM at any dilutions.
